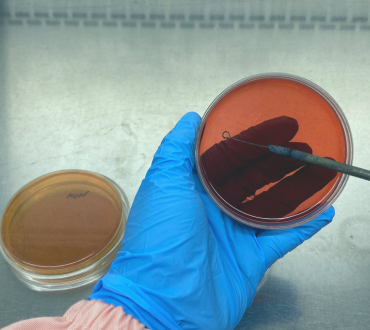
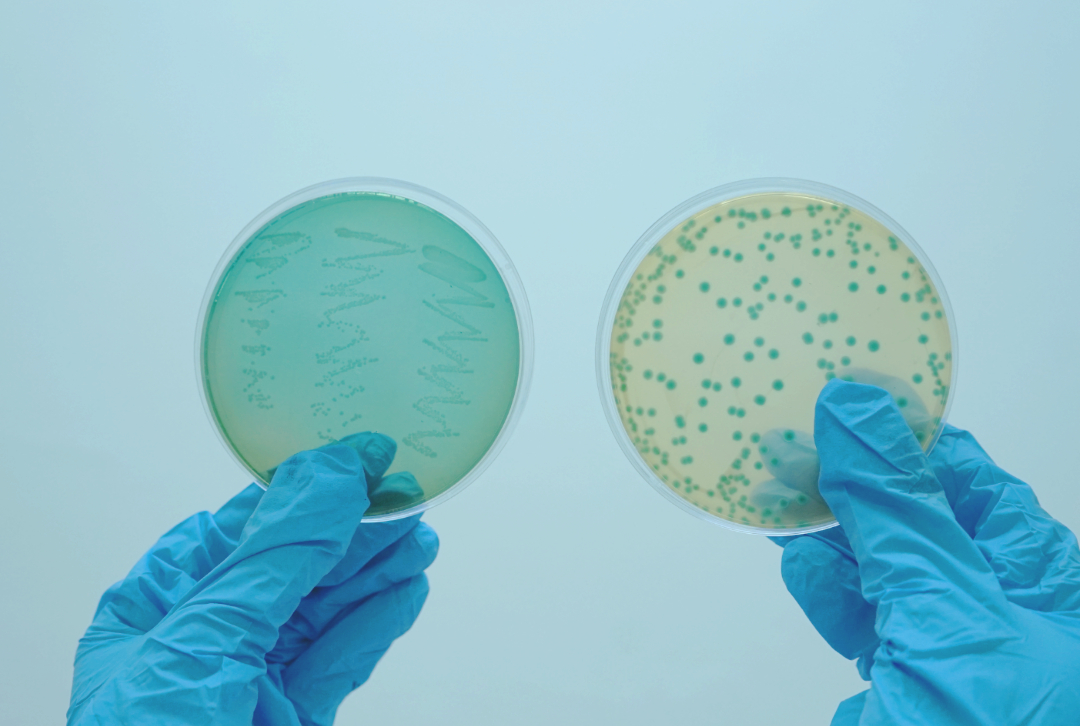

Catalogue
Our Capabilities
Packaging Tests
Dimension test
Dimension defines measurable aspects of space, such as length, width, height, and length
Pressure test
A precision machine for testing, pressing, or extruding materials under controlled conditions.
Visual test
Evaluates packaging appearance, ensuring visual quality and absence of detectable defects.
Glossiness test
Measures surface shine, reflectivity, and smoothness, affecting appearance in products.
Poly roll
Testing the physical strength of poly rolls (plastic packaging films) ensures their durability and performance during production, filling, distribution, and storage.
Adhesion test
The peel adhesion test measures the force required to remove a tape (e.g., packaging tape/"lakban") from a standard surface at a controlled angle and speed. This test evaluates bond strength and is critical for quality control in adhesive tape manufacturing.
Chemical Tests
Total Nitrogen
Dumas method quickly determines protein by combusting samples and measuring nitrogen content.
Proximate (NIR)
Proximate analysis using NIR rapidly determines moisture, protein, fat, carbohydrate and ash content accurately.
Total Dietary Fiber
Total dietary fiber is analyzed using enzymatic digestion, filtration, drying, weighing, and gravimetric methods.
Acidity
Measures the acidity level typically expressed as pH. It is crucial for quality control in food and beverage industries.
Mineral
Mineral analysis identifies and quantifies the mineral content within a sample or substance.
Sugar Profile
Total sucrose is analyzed by hydrolysis and titration to determines sucrose, reducing and total sugars
Vitamins
Analyzes vitamins in laboratory for analysis in milk and ensuring accurate quantification.
Proximate (Conventional)
Require chemical reagent to determine proximate analysis.
Oil Quality
Oil quality refers to purity, viscosity, acidity, and oxidation stability of the oil.
Heavy Metal
Heavy metal analysis in food samples detects toxic metals like lead, mercury, arsenic.
Assay
Assay analysis determines the concentration of a specific substance in a sample.
Fatty Acid
Fatty acid analysis identifies and quantifies fatty acids in oils or food samples.
Environmental Quality Testing
Environmental Quality Testing is a process to assess the condition of air, water, soil, and ecosystems by measuring pollutants, contaminants, and other parameters to ensures compliance with regulatory standards
Organic Compounds
Organic Compounds with Low Concentrations Commonly Analyzed by LC-MS/MS LC-MS/MS is especially powerful for detecting trace-level organic compounds (ppt to ppb levels) due to its high sensitivity and selectivity.
FT-NIR
FT-NIR (Fourier Transform Near-Infrared) spectroscopy analyzes materials based on molecular vibrations (overtone & combination bands) in the 780–2500 nm (12,800–4000 cm⁻¹) range.
Calibration
Dry Block Calibrator
Dry Block Calibrator performs precise temperature calibration for thermocouples, RTDs, and sensors.
Mass
Calibrates weighing instruments to ensure accurate measurements, crucial for quality control and regulatory compliance.
Fluke PT100 Sensor
Provides accurate temperature measurement for calibration, industrial, and laboratory applications.
Pressure
Service calibrates pressure-measuring instruments for accuracy, ensuring precise pressure control in industrial processes.
Microbiology Tests
Pathogen Testing
Pathogen bacteria analysis involves isolation, identification, and enumeration.
Other Bacteria Testing
Non-pathogenic bacteria are analyzed using culturing, and microscopy.
Probiotic Testing
Probiotic analysis evaluates viability and strain identification in products scientifically.
Microbiological Identification
Detecting, classifying, and analyzing microorganisms in food and beverage
Physical & Organoleptic Tests
Organoleptic Test
Organoleptic tests evaluate food’s appearance, texture, aroma, taste, and overall acceptability.
Physical Test
Evaluate various physical properties of a sample, such as pH, brix, density, dimension, netto, solubility, sediment and particle test.
Color (quantitative)
Measures surface color using a portable spectrophotometer for accuracy in product.
Leaking Tests
Leaking test refers to a process of identifying unwanted fluid or gas escapes in packaging integrity.